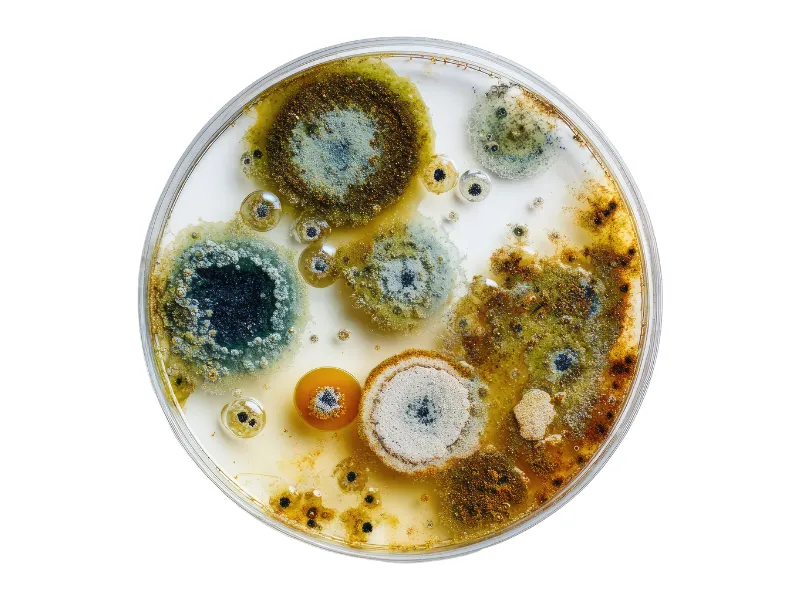
Miernik grzyba w powietrzu - pleśń widoczna pod mikroskopem
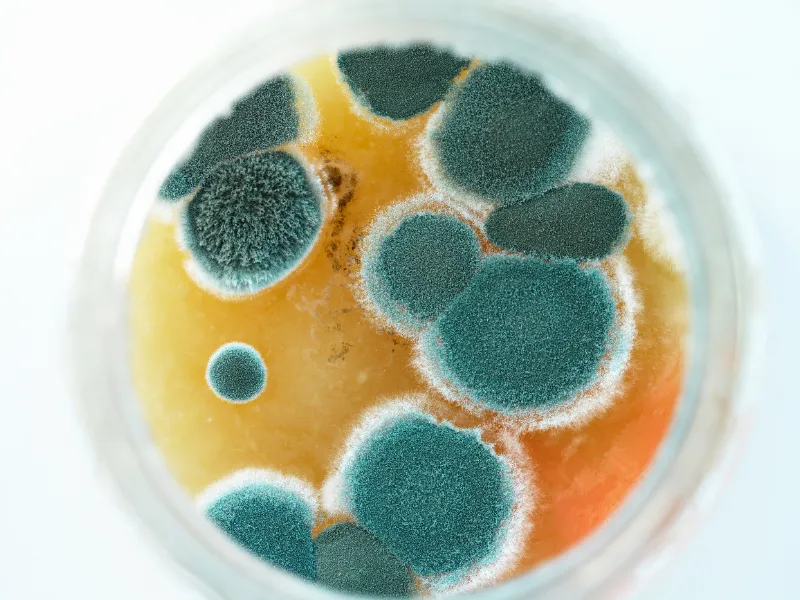
Pleśń pod mikroskopem

Wilgotność powietrza w domu nie powinna przekraczać 60%, a optymalnie powinna mieścić się w zakresie 40-60%. Jeśli jej poziom jest wyższy, we wnętrzu mogą pojawiać się wykwity pleśni, które zagrażają zdrowiu domowników i kondycji budynku.
Czym jest miernik grzyba?
Miernik grzyba w powietrzu to potoczne określenie na różne metody wykrywania pleśni w domu. Są to sposoby na sprawdzenie mikroklimatu, za pomocą specjalnych urządzeń pomiarowych. Warto je stosować, jeśli Twoje samopoczucie w ostatnim czasie się pogorszyło, odczuwasz nieprzyjemny zapach we wnętrzu, a szyby okienne często robią się mokre.

Pamiętaj, że do usunięcia grzyba konieczne jest usunięcie źródła problemu. W przeciwnym razie problem może powrócić. Do wychwytywania zarodników pomocny będzie oczyszczacz powietrza z grzybów pleśni, a do utrzymania odpowiedniej wilgotności kondensacyjny osuszacz powietrza.

Kiedy stosować miernik grzyba?
Miernik grzyba to rozwiązanie, które warto zastosować gdy:
- zmagasz się z problemem słabej wentylacji lub zawilgocenia,
- doskwierają Ci częste infekcje górnych dróg oddechowych i złe samopoczucie,
- na ścianach pojawiają się czarne plamy,
- odczuwasz ciągłe zmęczenie, rozdrażnienie i nerwowość,
- szyby w oknach często są zaparowane,
- we wnętrzu panuje zapach stęchlizny,
- wywieszone pranie schnie zbyt długo,
- wilgotność jest wyższa niż 60%.

Na czym polega badanie mikrobiologiczne powietrza?
Badanie mikrobiologiczne powietrza polega na pobraniu próbki powietrza, izolacji i identyfikacji mikroorganizmów (takich jak bakterie, grzyby pleśniowe czy drożdże).
Kolejnym krokiem jest ocena ich stężenia w celu sprawdzenia czystości mikrobiologicznej.
Główne metody badania mikrobiologicznego powietrza to:
- metoda sedymentacyjna – polega na naturalnym osiadaniu zarodników na płytkach Petriego z pożywką agarową. Jest to metoda tania, szybka, ale mniej precyzyjna niż metoda zderzeniowa lub filtracyjna. Jest też trudna do interpretacji.
- metoda zderzeniowa (aspiracyjna) – w tym sposobie specjalny przyrząd zasysa 1 m³ powietrza i „zderza” je z pożywką, licząc kolonie w przeliczeniu na m³. Cechuje ją wysoka precyzja.
- metoda filtracyjna – powietrze przechodzi przez filtr membranowy, na którym uwięzione są mikroorganizmy. Pozwala ona wykrywać też martwe formy (zależy od metody analitycznej) i pyłki pod mikroskopem.
Miernik grzyba w powietrzu — trzy dostępne rozwiązania
Miernik grzyba w powietrzu (zwany też testerem pleśni lub analizatorem mikrobiologicznym) stosuje się głównie do wykrywania zarodników grzybów pleśniowych w pomieszczeniach zamkniętych, w których istnieje podejrzenie skażenia.
Najlepiej używać go w sytuacjach, gdy pojawiają się objawy zdrowotne lub widoczne ślady wilgoci.
Spośród dostępnych testów na obecność pleśni w domu, wyróżniamy takie sposoby jak:
- testy płytkowe – najczęściej bazują na metodzie sedymentacyjnej,
- elektroniczne detektory pleśni – urządzenia do monitoringu stanu powietrza w domu,
- badania mykologiczne – usługa, która pozwala określić, jak bardzo powietrze jest zanieczyszczone, jaki rodzaj grzyba występuje w domu i jakimi sposobami z nim walczyć.
Testy płytkowe
Testy płytkowe to cały zestaw służący do badania stężenia zarodników pleśni w powietrzu. Popularne produkty takie jak grzybtest lub Aircheck pozwalają na szybkie uzyskanie efektów.
Aby wykonać test, wystarczy poddać próbkę na ekspozycję zarodników pleśni na 30-120 minut i zostawić w inkubacji na ok. 10 dni. Po tym czasie można samemu przeliczyć kolonie lub odesłać próbkę do analizy laboratoryjnej.
Testy płytkowe opierają się na metodzie sedymentacyjnej (opadowej). Innymi słowy, jest to zjawisko naturalnego opadania cząstek na wybrane podłoże – w testach są to płytki z pożywką agarową.

Metoda sedymentacyjna jest relatywnie tania i daje szybkie efekty, dlatego jest najczęściej wybierana w domach i mieszkaniach. Jej koszt to około 100 – 250 zł. Pokazuje ogólną liczbę wyhodowanych kolonii, pozwala oszacować skalę zanieczyszczenia, a także określić wygląd i gatunek mikroorganizmów.
Warto jednak wspomnieć, że sedymentacja nie ujawnia wszystkiego. Nie pokaże przyczyny problemu, nie daje wiarygodnej ilościowej oceny stężenia zarodników na metr sześcienny i nie wykrywa problemów ukrytych w przegrodach.
Co więcej, metoda sedymentacyjna jest wrażliwa na dane środowiskowe, które są zmienne. Należy do nich cyrkulacja powietrza i działanie systemów wentylacji.
Wyniki z płytek sedymentacyjnych bardzo zależą od ruchu powietrza, czasu ekspozycji i tego, że wykrywają głównie organizmy zdolne do wzrostu na danej pożywce.
Test płytkowy ma więc wartość orientacyjną i nie zastępuje profesjonalnej diagnostyki.

Elektroniczne detektory pleśni
Elektroniczne detektory pleśni służą do wykrywania zagrożeń mikrobiologicznych. Proste urządzenia mierzą podstawowe parametry jak wilgotność powietrza i temperaturę.
Bardziej zaawansowane modele analizują kilka parametrów na raz i zapamiętują dane w pamięci. Niektóre z nich analizują m.in. MVOC, czyli lotne związki organiczne związane z aktywnością mikroorganizmów.
Technologia detekcji lokalizuje strefy zagrożenia jeszcze przed rozwojem kolonii pleśni. Warto dodać, że takie urządzenie służy do prewencji. Należy go używać zanim problem rozwinie się na dobre.
Jeśli chodzi o cenę, najprostsze urządzenia kupisz za 30-100 zł, bardziej zaawansowane mierniki kosztują 200-750 zł, a najdokładniejsze urządzenia z wieloma funkcjami dodatkowymi to koszt rzędu ok. 1000 zł.

Badania mykologiczne
Do najbardziej zaawansowanych metod testowych należy badanie mykologiczne przeprowadzane w domu. Służą one do identyfikacji gatunków pleśni i grzybów oraz powodów ich rozwoju.
Jest to profesjonalna usługa, która obejmuje pomiary wilgotności, badania kamerą termowizyjną oraz pobranie próbek materiału do analizy laboratoryjnej. Specjaliści najczęściej stosują metody zderzeniowe, które są precyzyjne i dają więcej potrzebnych informacji.
Największym atutem takich testów jest identyfikacja rodzaju grzyba, która pozwala dobrać odpowiednią metodę jego usuwania i zapobiegania nawrotom.
Wadą tej usługi jest wysoka cena. Profesjonalna ekspertyza mykologiczna, która obejmuje raport i porady to wydatek rzędu 1500–2500 zł netto. W ekstremalnych przypadkach warto zainwestować taką kwotę i zlecić badanie mykologowi budowlanemu.

Jak interpretować wyniki?
- Niski wynik i wyraźne objawy – jeśli wynik testu jest niski, ale w domu pojawiła się pleśń, wilgoć lub nieprzyjemny zapach, warto zrobić dokładniejsze badania. W takim wypadku polecamy sprawdzić warunki wilgotnościowe i przegrody, bo źródło problemu może być ukryte.
- Wyższy wynik w jednym pomieszczeniu – oznacza, że właśnie tam należy szukać przyczyny problemu. Zwykle w takim wypadku przyczyną jest zła wentylacja lub wilgoć pojawiająca się w przegrodach.
- Wysoki wynik bez wyraźnych objawów – sugeruje, że warto zrobić diagnostykę budowlaną. W takim wypadku problem najczęściej dotyczy konstrukcji budynku lub przestrzeni, które są dla nas niewidoczne.

Jak zmierzyć wilgotność w domu?
Miernik grzyba w domu może pośrednio wskazywać na ryzyko obecności pleśni lub warunki sprzyjające jej rozwojowi. Aby uniknąć problemu, polecamy na bieżąco monitorować poziom wilgotności we wnętrzu.
Aby określić, ile wody znajduje się w powietrzu, wystarczy użyć higrometru (wilgotnościomierza) lub domowej stacji pogodowej. Takie urządzenia kupisz za kilkadziesiąt złotych w sklepach internetowych lub budowlanych.
Do monitorowania i utrzymania optymalnej wilgotności służy osuszacz powietrza. Warto się w niego zaopatrzyć jeśli zauważysz wysoką kondensację pary wodnej.
Zaparowane okna, nieprzyjemny zapach, czy długo schnące pranie to sygnały alarmowe, które powinny wezwać Cię do działania.

Jak usunąć grzyba w domu? Plan działania w skrócie
Jeśli w Twoim domu pojawiły się wykwity pleśni, działania powinny nabrać tempa. Grzyb na ścianie i suficie to zagrożenie dla zdrowia domowników oraz kondycji budynku.
Oto jak działać krok po kroku:
- Po pierwsze zidentyfikuj źródło problemu, sprawdź, czy nie ma przecieków, czy wentylacja jest sprawna i skąd bierze się wilgoć. Właśnie na tym etapie należy wykonać testy i badania.
- Oceń skalę problemu i zbierz potrzebne materiały. Pamiętaj o środkach ochrony osobistej. Poza narzędziami potrzebne będą profesjonalne lub domowe środki grzybobójcze.
- Następnie wyczyść twarde, nieporowate powierzchnie wodą z detergentem lub postępuj zgodnie z etykietą środka. W wielu przypadkach konieczne jest usunięcie porażonych materiałów porowatych, a przy zagrzybionym tynku — skucie jego fragmentu.
- W kolejnym kroku nałóż preparat grzybobójczy zgodnie z instrukcją producenta. Jeśli problem jest poważny, zleć pracę profesjonalnej firmie.
- Zastosuj wentylator lub osuszacz powietrza. Ostatnie z wymienionych rozwiązań pozwoli Ci zmniejszyć wilgotność i poprawić przepływ powietrza. Do usuwania zarodników pleśni zastosuj oczyszczacz powietrza z filtrem HEPA, który będzie stanowić wsparcie podczas osuszania powietrza.
- Ostatnim krokiem jest pomalowanie ścian farbą antygrzybiczą.
Aby zapobiec nawrotom grzyba, pamiętaj, aby codziennie wietrzyć pomieszczenia, kontrolować poziom wilgotności i unikać wychłodzenia wnętrz.

Miernik grzyba w powietrzu. Podsumowanie
Miernik grzyba w powietrzu (testy płytkowe, detektory elektroniczne lub badania mykologiczne) może pośrednio wskazywać na problem wilgoci i zanieczyszczenia biologicznego.
Domowe testy mogą orientacyjnie wskazywać na obecność zanieczyszczenia biologicznego, ale nie służą do wiarygodnego oznaczania mikotoksyn ani pełnej oceny ryzyka zdrowotnego.
Rodzaje badań mikrobiologicznych powietrza możemy podzielić na metodę sedymentacyjną (można ją przeprowadzić samodzielnie w domu), zderzeniową (jest nieco bardziej precyzyjna) i filtracyjną.
Testy należy przeprowadzić przy takich objawach jak kaszel, wyczuwalny zapach stęchlizny, czy zaparowane okna. Pamiętaj, że zdrowe powietrze to wilgotność w zakresie 40-60%. Warunki, w których powietrze przekracza 60%, sprzyjają powstawaniu pleśni.
Jeśli w Twoim wnętrzu pojawił się grzyb, zadbaj o odpowiednią cyrkulację powietrza, znajdź i usuń źródło problemu, a następnie przejdź do kolejnych kroków. Konieczne jest usunięcie zainfekowanych powierzchni, zastosowanie preparatu grzybobójczego i pomalowanie ścian farbą antygrzybiczą.
Pomocne są również profesjonalne osuszacze powietrza czy domowe wentylatory. Po usunięciu grzyba pamiętaj o regularnym wietrzeniu pomieszczeń.
FAQ
Wyniki hodowli wyraża się zwykle w CFU/m³, ale ich interpretacja zależy od metody poboru, czasu, wentylacji, warunków zewnętrznych i porównania z próbką zewnętrzną. Nie istnieje więc jedna, powszechnie uznana norma zdrowotna dla mieszkań.
Testy stosuj przy wilgotności powyżej 60%, odczuwalnym zapachu stęchlizny, alergiach lub zaparowanych szybach.
Najpopularniejsze metody pomiaru to sedymentacja (płytki agarowe, 30–120 min), metoda zderzeniowa (aspiracyjna) i filtracyjna.
Niski wynik nie wyklucza problemu, zwłaszcza gdy w domu widać pleśń, czuć stęchliznę lub występuje zawilgocenie. Wynik wysoki oznacza, że trzeba poszukać źródła wilgoci. W takiej sytuacji warto zlecić bardziej zaawansowane testy dla identyfikacji gatunków grzybów.
Detektor elektroniczny mierzy wilgotność, temperaturę, a bardziej zaawansowane modele także MVOC, czyli lotne związki organiczne. Taki sprzęt nie liczy natomiast kolonii, ale sygnalizuje ryzyko występowania pleśni.
Testy płytkowe to koszt rzędu 100-250 zł; detektory kupisz za 30-1000 zł, a testy mykologiczne to koszt rzędu 1500-2500 zł.
Przede wszystkim osusz źródło, dezynfekuj miejsce powstania za pomocą preparatów, a następnie usuń i wymień porażone materiały budowlane na nowe. Przy dużym skażeniu warto skorzystać z pomocy specjalisty.
Źródła
Ocena stopnia skażenia powietrza zarodnikami grzybów pleśniowych jako istotny czynnik ekspertyzy mikologicznej, Anna Wiejak, Prace Instytutu Techniki Budowlanej – Kwartalnik, rok wydania: 2021, strona internetowa: yadda.icm.edu
Wilgoć w obiektach budowlanych. Problematyka badań i przyczyn zawilgocenia, Maciej Trochonowicz, Budownictwo i Architektura 7, rok wydania: 2010, strona internetowa: yadda.icm.edu
Testy na pleśń i grzyby w powietrzu: kiedy mają sens, a kiedy dają fałszywy spokój, Piotr Gramza, Publikacja: 17 marca 2026 roku, strona internetowa: inspekcjadomu.pl





